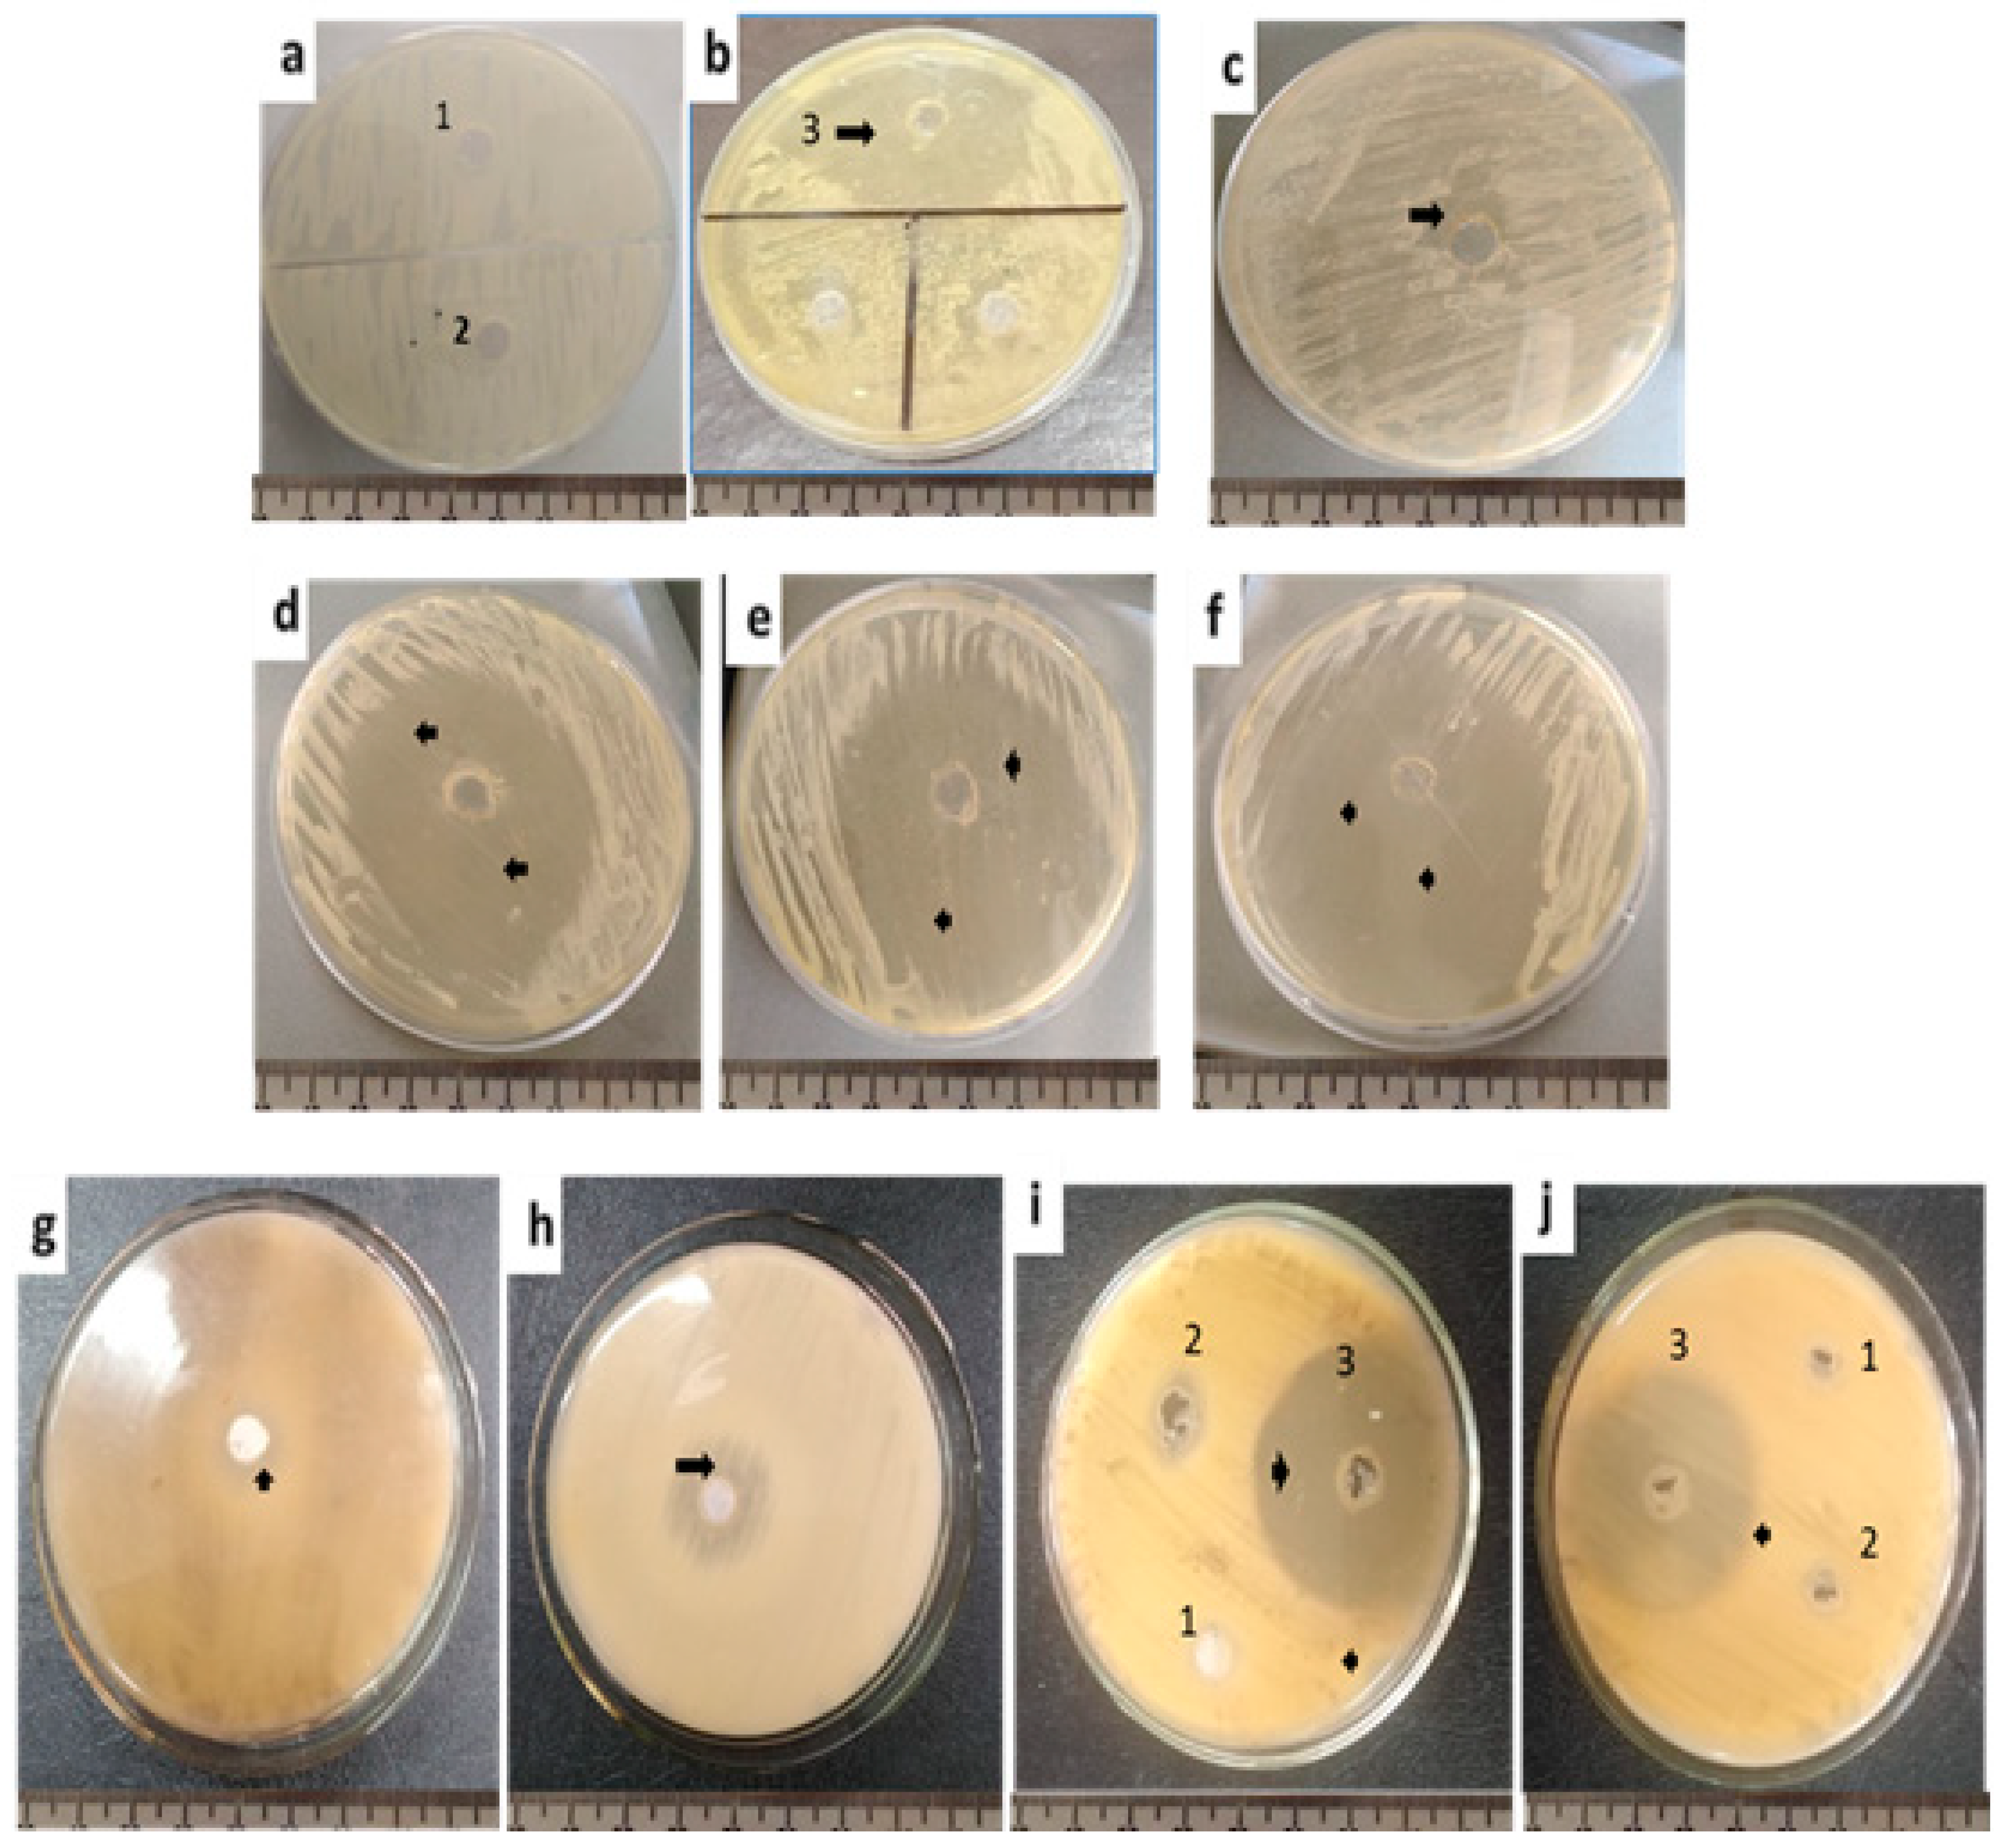
Molecules 27 03170 g001 Molecules 27 03170 g001

Antifungal Activity of Soft Tissue Extract from the Garden Snail Helix aspersa (Gastropoda, Mollusca)
Abstract
1. Introduction
2. Results
Identified Compounds Using LC-MS-MS Analysis
3. Discussion
4. Materials and Methods
4.1. Sample Collection and Care
4.2. Tissue Extraction
4.3. Antifungal Assays
4.4. Chemical Analysis of Extracts
4.5. Statistical Analysis
Supplementary Materials
Author Contributions
Funding
Institutional Review Board Statement
Informed Consent Statement
Data Availability Statement
Acknowledgments
Conflicts of Interest
References
- Bonnemain, B. Helix and Drugs: Snails for Western Health Care from Antiquity to the Present. Evid. Based Complement. Altern. Med. 2005, 2, 583043. [Google Scholar] [CrossRef] [PubMed]
- González, Y.; Tanaka, A.S.; Hirata, I.Y.; del Rivero, M.A.; Oliva, M.L.; Araujo, M.S.; Chávez, M.A. Purification and partial characterization of human neutrophil elastase inhibitors from the marine snail Cenchritis muricatus (Mollusca). Comp. Biochem. Physiol. Part A Mol. Integr. Physiol. 2007, 146, 506–513. [Google Scholar] [CrossRef] [PubMed]
- Ulagesan, S.; Kim, H.J. Antibacterial and Antifungal Activities of Proteins Extracted from Seven Different Snails. Appl. Sci. 2018, 8, 1362. [Google Scholar] [CrossRef]
- Dhiman, V.; Pant, D. Human health and snails. J. Immunoass. Immunochem. 2021, 42, 211–235. [Google Scholar] [CrossRef]
- Gentili, V.; Bortolotti, D.; Benedusi, M.; Alogna, A.; Fantinati, A.; Guiotto, A.; Turrin, G.; Cervellati, C.; Trapella, C.; Rizzo, R.; et al. HelixComplex snail mucus as a potential technology against O3 induced skin damage Valentina. PLoS ONE 2020, 15, e0229613. [Google Scholar] [CrossRef]
- Ahmad, A.M.; Ali, M.; Muazu, L.; Abdallah, M.S.; Zungum, I.U. Assessment of antibacterial activity of snail Archachatina marginata slime on some clinical wound isolate. Innov. Int. J. Med. Pharm. Sci. 2021, 6, 8–11. [Google Scholar]
- Krumova, E.; Dolashka, P.; Abrashev, R.; Velkova, L.; Dolashki, A.; Daskalova, A.; Dishliyska, V.; Atanasov, V.; Kaynarov, D.; Angelova, M. Antifungal activity of separated fractions from the hemolymph of marine snail Rapana venosa. Bulg. Chem. Commun. 2021, 53, 42–48. [Google Scholar] [CrossRef]
- Aleksova, M.; Velkova, L.P.; Dolashka, P.; Radeva, G. Antibacterial activity of bioactive fractions from mucus and hemolymph of different snails species and crab. Bulg. Chem. Commun. 2021, 53, 22–26. [Google Scholar] [CrossRef]
- Vassilev, N.; Simova, S.; Dangalov, M.; Velkova, L.; Atanassov, V.; Dolashki, A.; Dolashka, P. A 1H NMR based study of metabolites profiling of garden snail Helix lucorum hemolymph. Bulg. Chem. Commun. 2021, 53, 49–56. [Google Scholar] [CrossRef]
- López-Abarrategui, C.; Alba, A.; Silva, O.N.; Reyes-Acosta, O.; Vasconcelos, I.M.; Oliveira, J.T.; Migliolo, L.; Costa, M.P.; Costa, C.R.; Silva, M.R.; et al. Functional characterization of a synthetic hydrophilic antifungal peptide derived from the marine snail Cenchritis muricatus. Biochimie 2012, 94, 968–974. [Google Scholar] [CrossRef]
- Subavathy, P.; Thilaga, R.D.; Shibana, C. Screening of marine gastropod cypraea arabica for antibacterial and antifungal activity. Int. J. Curr. Res. 2015, 7, 19995–20001. [Google Scholar]
- Periyasamy, N.; Srinivasan, M.; Balakrishnan, S. Antimicrobial activities of the tissue extracts of Babylonia spirata Linnaeus, 1758 (Mollusca: Gastropoda) from Thazhanguda, southeast coast of India. Asian Pac. J. Trop. Biomed. 2012, 2, 36–40. [Google Scholar] [CrossRef]
- Gnat, S.; Łagowski, D.; Nowakiewicz, A.; Dylazg, A. A global view on fungal infections in humans and animals: Infections caused by dimorphic fungi and dermatophytoses. J. Appl. Microbiol. 2021, 131, 2688–2704. [Google Scholar] [CrossRef] [PubMed]
- Bongomin, F.; Gago, S.; Oladele, R.O.; Denning, D.W. Global and Multi-National Prevalence of Fungal Diseases—Estimate Precision. J. Fungi 2017, 3, 57. [Google Scholar] [CrossRef] [PubMed]
- Suresh, M.; Rath, P.K.; Panneerselvam, A.; Dhanasekaran, D.; Thajuddin, N. Antifungal activity of selected Indian medicinal plant salts. J. Glob. Pharma Technol. 2010, 2, 71–74. [Google Scholar]
- Saranya, S.; Moorthy, K.; Malar, S.S.A.S.; Punitha, T.; Vinodhini, R.; Bhuvaneshwari, M.; Kanimozhi, C. Prevalence and antifungal susceptibility pattern of Candida albicans from low socio-economic group. Int. J. Pharm. Pharm. Sci. 2014, 6, 158–162. [Google Scholar]
- Casadevall, A. Fungal Diseases in the 21st Century: The Near and Far Horizons. Pathog. Immun. 2018, 3, 183–196. [Google Scholar] [CrossRef]
- Lin, S.; Schranz, J.; Teutsch, S.M. Aspergillosis Case-Fatality Rate: Systematic Review of the Literature. Clin. Infect. Dis. 2001, 32, 358–366. [Google Scholar] [CrossRef]
- Hill, J.M.; Atkins, A.R.; Loughnan, M.L.; Jones, A.; Adams, D.A.; Martin, R.C.; Lewis, R.J.; Craik, D.J.; Alewood, P.F. Conotoxin TVIIA, a novel peptide from the venom of Conus tulipa. Eur. J. Biochem. 2000, 267, 4642–4648. [Google Scholar] [CrossRef]
- Myers, R.A.; Cruz, L.J.; Rivier, J.E.; Olivera, B.M. Conus peptides as chemical probes for receptors and ion channels. Chem. Rev. 1993, 93, 1923–1936. [Google Scholar] [CrossRef]
- Terlau, H.; Shon, K.J.; Grilley, M.; Stocker, M.; StuÈhmer, W.; Olivera, B. Strategy for rapid immobilization of prey by a fish-hunting marine snail. Nature 1996, 381, 148–151. [Google Scholar] [CrossRef] [PubMed]
- Massilia, G.R.; Schininà, M.; Ascenzi, P.; Polticelli, F. Contryphan-Vn: A Novel Peptide from the Venom of the Mediterranean Snail Conus ventricosus. Biochem. Biophys. Res. Commun. 2001, 288, 908–913. [Google Scholar] [CrossRef]
- Hussain, F.; Jahan, N.; Rahman, K.-U.; Sultana, B.; Jamil, S. Identification of Hypotensive Biofunctional Compounds of Coriandrum sativum and Evaluation of Their Angiotensin-Converting Enzyme (ACE) Inhibition Potential. Oxidative Med. Cell. Longev. 2018, 2018, 4643736. [Google Scholar] [CrossRef] [PubMed]
- Sánchez-Rabaneda, F.; Jáuregui, O.; Casals, I.; Andrés-Lacueva, C.; Izquierdo-Pulido, M.; Lamuela-Raventós, R.M. Liquid chromatographic/electrospray ionization tandem mass spectrometric study of the phenolic composition of cocoa (Theobroma cacao). Biol. Mass Spectrom. 2003, 38, 35–42. [Google Scholar] [CrossRef]
- Vanhaecke, L.; Bussche, J.V.; Wille, K.; Bekaert, K.; De Brabander, H.F. Ultra-high performance liquid chromatography–tandem mass spectrometry in high-throughput confirmation and quantification of 34 anabolic steroids in bovine muscle. Anal. Chim. Acta 2011, 700, 70–77. [Google Scholar] [CrossRef]
- Fang, T.; Wang, Y.; Ma, Y.; Su, W.; Bai, Y.; Zhao, P. A rapid LC/MS/MS quantitation assay for naringin and its two metabolites in rats plasma. J. Pharm. Biomed. Anal. 2006, 40, 454–459. [Google Scholar] [CrossRef]
- Allam, G.; Abuelsaad, A.S.A. In vitro and in vivo effects of hesperidin treatment on adult worms of Schistosoma mansoni. J. Helminthol. 2014, 88, 362–370. [Google Scholar] [CrossRef]
- Lahlou, M. Study of the molluscicidal activity of some phenolic compounds: Structure-activity relationship. Pharm. Biol. 2004, 42, 258–261. [Google Scholar] [CrossRef]
- Fedoreyev, S.; Pokushalova, T.; Veselova, M.; Glebko, L.; Kulesh, N.; Muzarok, T.; Seletskaya, L.; Bulgakov, V.; Zhuravlev, Y. Isoflavonoid production by callus cultures of Maackia amurensis. Fitoterapia 2000, 71, 365–372. [Google Scholar] [CrossRef]
- Tuli, H.S.; Tuorkey, M.J.; Thakral, F.; Sak, K.; Kumar, M.; Sharma, A.K.; Sharma, U.; Jain, A.; Aggarwal, V.; Bishayee, A. Molecular Mechanisms of Action of Genistein in Cancer: Recent Advances. Front. Pharmacol. 2019, 10, 1336. [Google Scholar] [CrossRef]
- Luo, Y.; Wang, S.-X.; Zhou, Z.-Q.; Wang, Z.; Zhang, Y.-G.; Zhang, Y.; Zhao, P. Apoptotic effect of genistein on human colon cancer cells via inhibiting the nuclear factor-kappa B (NF-κB) pathway. Tumor Biol. 2014, 35, 11483–11488. [Google Scholar] [CrossRef] [PubMed]
- Miao, Z.-Y.; Xia, X.; Che, L.; Song, Y.-T. Genistein attenuates brain damage induced by transient cerebral ischemia through up-regulation of Nrf2 expression in ovariectomized rats. Neurol. Res. 2018, 40, 689–695. [Google Scholar] [CrossRef] [PubMed]
- Sivanesan, D.; Marimuthu, P.; Hörmann, V.; Kumi-Diaka, J.; Rathinavelu, A. Induction of apoptosis in HeLa cells via caspase activation by resveratrol and genistein. J. Med. Food 2013, 16, 139–146. [Google Scholar] [CrossRef]
- Kajiwara, M.; Kuraku, S.; Kurokawa, T.; Kato, K.; Toda, S.; Hirose, H.; Takahashi, S.; Shibata, Y.; Iguchi, T.; Matsumoto, T.; et al. Tissue preferential expression of estrogen receptor gene in the marine snail, Thais clavigera. Gen. Comp. Endocrinol. 2006, 148, 315–326. [Google Scholar] [CrossRef]
- Baulieu, E.; Schumacher, M. Progesterone as a neuroactive neurosteroid, with special reference to the effect of progesterone on myelination. Hum. Reprod. 2000, 15, 1–13. [Google Scholar] [CrossRef][Green Version]
- Brucker, M.C.; King, T.L. Pharmacology for Women’s Health; Issue Jones & Bartlett Publishers: Burlington, MA, USA, 2017. [Google Scholar]
- Lenasi, H.; Bavec, A.; Zorko, M. Membrane-bound progesterone receptors coupled to G proteins in the fungus Rhizopus nigricans. FEMS Microbiol. Lett. 2002, 213, 97–101. [Google Scholar] [CrossRef][Green Version]
- Loose, D.S.; Schurman, D.J.; Feldman, D. A corticosteroid binding protein and endogenous ligand in C. albicans indicating a possible steroid-receptor system. Nature 1981, 293, 477–479. [Google Scholar] [CrossRef]
- Feldman, D.; Toktst, L.G.; Stathis, P.A.; Miller, S.C.; Kurzt, W.; Harveyt, D. Identification of 17fi-estradiol as the estrogenic substance in Saccharomyces cerevisiae (yeast/steroid hormone/estrogen receptor). Biochemistry 1984, 81, 4722–4726. [Google Scholar]
- Clemons, K.V.; Schär, G.; Stover, E.P.; Stevens, D.A.F. Dermatophyte-hormone relationships: Characterization of progesterone-binding specificity and growth inhibition in the genera Trichophyton and Microsporum. J. Clin. Microbiol. 1988, 26, 2110–2115. [Google Scholar] [CrossRef]
- Jeraj, N.; Lenasi, H.; Breskvar, K. The involvement of cAMP in the growth inhibition of filamentous fungus Rhizopus nigricans by steroids. FEMS Microbiol. Lett. 2005, 242, 147–154. [Google Scholar] [CrossRef][Green Version]
- Alves, C.T.; Ferreira, I.; Barros, L.; Sónia Silva, S.; Azeredo, J.; Henriques, M.; Azeredo, J.; Henriques, M. Antifungal activity of phenolic compounds identified in flowers from North Eastern Portugal against Candida species. Future Microbiol. 2014, 9, 139–146. [Google Scholar] [CrossRef] [PubMed]
- Al Aboody, M.S.; Mickymaray, S. Anti-Fungal Efficacy and Mechanisms of Flavonoids. Antibiotics 2020, 9, 45. [Google Scholar] [CrossRef] [PubMed]
- Khan, A.; Ahmad, A.; Akhtar, F.; Yousuf, S.; Xess, I.; Khan, L.A.; Manzoor, N. Induction of oxidative stress as a possible mechanism of the antifungal action of three phenylpropanoids. FEMS Yeast Res. 2011, 11, 114–122. [Google Scholar] [CrossRef] [PubMed]
- Lagrouh, F.; Dakka, N.; Bakri, Y. The antifungal activity of Moroccan plants and the mechanism of action of secondary metabolites from plants. J. Mycol. Med. 2017, 27, 303–311. [Google Scholar] [CrossRef] [PubMed]
- Walters, D.; Raynor, L.; Mitchell, A.; Walker, R.; Walker, K. Antifungal activities of four fatty acids against Plant Pathogenic fungi. Mycopathologia 2004, 157, 87–90. [Google Scholar] [CrossRef]
- Avis, T.J.; Bélanger, R.R. Specificity and Mode of Action of the Antifungal Fatty Acid cis-9-Heptadecenoic Acid Produced by Pseudozyma flocculosa. Appl. Environ. Microbiol. 2001, 67, 956–960. [Google Scholar] [CrossRef]
- Liu, S.; Ruan, W.; Li, J.; Xu, H.; Wang, J.; Gao, Y.; Wang, J. Biological Control of Phytopathogenic Fungi by Fatty Acids. Mycopathologia 2008, 166, 93–102. [Google Scholar] [CrossRef]
- Juárez, Z.N.; Hernández, L.R.; Bach, H.; Sánchez-Arreola, E.; Bach, H. Antifungal activity of essential oils extracted from Agastache mexicana ssp. xolocotziana and Porophyllum linaria against post-harvest pathogens. Ind. Crops Prod. J. 2015, 74, 178–182. [Google Scholar] [CrossRef]
- Erdogan Eliuz, E.A.; Yabalak, E.; Gökşen, G.; Ayas, D. Chemical composition, antifungal activity, antifungal mechanism and interaction manner of the fatty acid of Prunus mahaleb L. with fluconazole. Int. J. Environ. Health Res. 2021, 31, 1–13. [Google Scholar] [CrossRef]
- Bauer, A.W.; Kirby, W.M.; Sherris, J.C.; Turck, M. Antibiotic susceptibility testing by a standardized single disk method. Am. J. Clin. Pathol. 1966, 3, 1066–1069. [Google Scholar] [CrossRef]
- Elrasoul, A.S.A.; Mousa, A.A.; Orabi, S.H.; Mohamed, M.A.E.-G.; Gad-Allah, S.M.; Almeer, R.; Abdel-Daim, M.M.; Khalifa, S.A.M.; El-Seedi, H.R.; Eldaim, M.A.A. Antioxidant, Anti-Inflammatory, and Anti-Apoptotic Effects of Azolla pinnata Ethanolic Extract against Lead-Induced Hepatotoxicity in Rats. Antioxidants 2020, 9, 1014. [Google Scholar] [CrossRef] [PubMed]
indicates a significant difference between tissue extract and concentration;
indicates a significant difference between extracting solvents (ANOVA, p ≤ 0.05).
indicates a significant difference between tissue extract and concentration;
indicates a significant difference between extracting solvents (ANOVA, p ≤ 0.05).

| Compound Name | Parent Mass (m/z) | M.F | Fragments from the Raw Mass Spectrum | Fragments from GNPS Database | Reference |
|---|---|---|---|---|---|
| Genistein 1,2 | 271.48900 | C15H10O5 | 144.96, 148.98, 152.92, 214.96, 255.03, 242.95 | 144.98, 148.39, 152.94, 215.06, 255.01, 242.02 | |
| Luteolin 1,2,3,4 | 287.43500 | C15H10O6 | 110.98, 134.96, 152.90, 161.00, 241.00, 259.00, 269.00 | 111.00, 135.00, 153.00, 160.98, 241.04, 259.04, 269.05 | [23,24] |
| Linoleic acid 1,2 | 280.4 g | C18H32O2 | 153,95, 176.90, 219.07, 286.03 | 153,02, 177.06, 219.07, 286.10 | |
| 11-alpha-Acetoxyprogesterone 1,2,3,4 | 372.50800 | C23H32O4 | 172.95, 277.14, 294.19, 312.15 | 173.10, 277.18, 295.20, 313.22 | [25] |
| Hesperidin | 611.25400 | C28H34O15 | 303.05, 345.05, 413.06, 449.07, 465.07, 489.10, 557.20, 593.29 | 303.05, 345.05, 413.06, 449.07, 465.07, 489.10, 557.20, 593.29 | [26] |
Publisher’s Note: MDPI stays neutral with regard to jurisdictional claims in published maps and institutional affiliations. |
© 2022 by the authors. Licensee MDPI, Basel, Switzerland. This article is an open access article distributed under the terms and conditions of the Creative Commons Attribution (CC BY) license (https://creativecommons.org/licenses/by/4.0/).
Share and Cite
Azeem, H.H.A.-E.; Osman, G.Y.; El-Seedi, H.R.; Fallatah, A.M.; Khalifa, S.A.M.; Gharib, M.M. Antifungal Activity of Soft Tissue Extract from the Garden Snail Helix aspersa (Gastropoda, Mollusca). Molecules 2022, 27, 3170. https://doi.org/10.3390/molecules27103170
Azeem HHA-E, Osman GY, El-Seedi HR, Fallatah AM, Khalifa SAM, Gharib MM. Antifungal Activity of Soft Tissue Extract from the Garden Snail Helix aspersa (Gastropoda, Mollusca). Molecules. 2022; 27(10):3170. https://doi.org/10.3390/molecules27103170
Chicago/Turabian StyleAzeem, Hoda H. Abd-El, Gamalat Y. Osman, Hesham R. El-Seedi, Ahmed M. Fallatah, Shaden A. M. Khalifa, and Mohamed M. Gharib. 2022. "Antifungal Activity of Soft Tissue Extract from the Garden Snail Helix aspersa (Gastropoda, Mollusca)" Molecules 27, no. 10: 3170. https://doi.org/10.3390/molecules27103170
APA StyleAzeem, H. H. A.-E., Osman, G. Y., El-Seedi, H. R., Fallatah, A. M., Khalifa, S. A. M., & Gharib, M. M. (2022). Antifungal Activity of Soft Tissue Extract from the Garden Snail Helix aspersa (Gastropoda, Mollusca). Molecules, 27(10), 3170. https://doi.org/10.3390/molecules27103170

